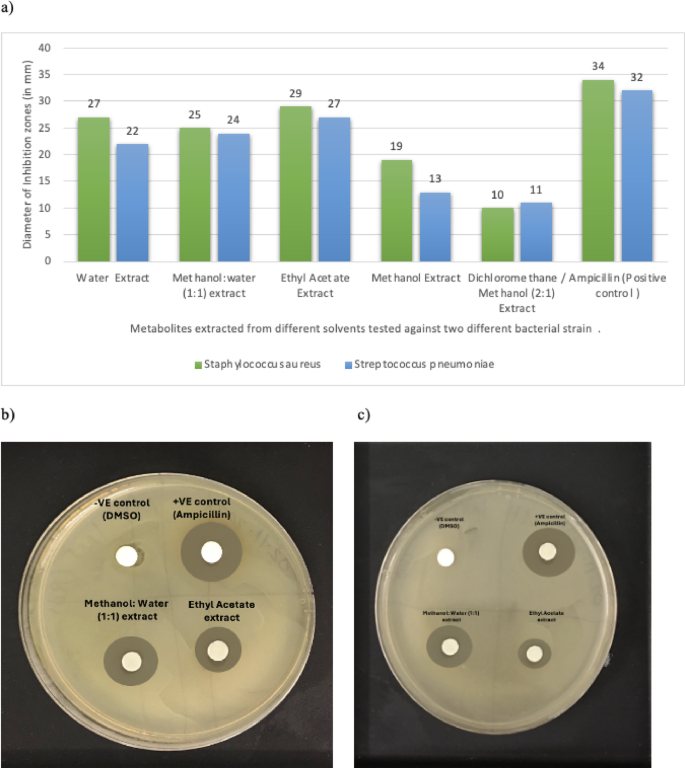
figure 8

Abstract
Origanum ramonense is a rare and underexplored aromatic (Lamiaceae family) native to the Mediterranean region, but despite its prospects as a medicinal plant, there is a shortage of spectrometry based metabolic profiling of this plant. Thus, the objective of this study was to carry out a detailed investigation of the metabolic profile of Origanum ramonense extracts using multiple solvents (methanol, methanol/water, ethyl acetate, dichloromethane/methanol, and hot water) of varying polarity, and further assess its bioactive potential. Using analytical tools such as NMR and GC/MS, we identified functional groups of plant metabolites and further employed multiple assays such as DPPH (antioxidant activity) and the Folin–Ciocalteu method to understand the plant’s bioactivity. The extracts were found to be rich with polyphenolic compounds (17.8–107.2 mg Gallic acid per gram extract) and had strong antioxidant activity (IC50 5.8–128.5). The promising bioactivity was validated not only by results for in-vitro anticancer and (MCF-7 and HeLa cells) antibacterial tests (S. aureus and S. pneumoniae) but also in-silco molecular docking further showed the potential of antiviral activity of the extracted metabolites against SARS-CoV. These findings highlight O. ramonense as a valuable source of natural antioxidants and bioactive compounds, underscoring the need for further research into its medicinal properties.
Similar content being viewed by others
Introduction
For centuries, all human civilizations have relied on a diverse range of plants for both food and medicine, harnessing their properties to prevent and cure various diseases1,2,3,4,5. Plants with medicinal properties have a plethora of metabolites that exhibit notable therapeutic effects but since the 19th Century, traditional medicinal herbs and phytotherapy have been overlooked and underappreciated. However, increased recognition that synthetic pharmaceutical products have significant limitations, has led to a resurging and growing interest in traditional medicinal herbs, prompting the development of diverse novel plant-derived therapeutics6,7,8,9,10,11,12,13,14,15,16,17,18.
Plants from the Lamiaceae family, especially the members of the Origanum genus, have rich sources of essential volatile oils that have been traditionally employed for their healing properties19,20. These oils are known for their wide array of pharmacological effects such as anti-inflammatory, wound-healing, antidiabetic, antihyperlipidemic, anti-obesity, anti-malarial, antiproliferative, and even anticancer properties6,7,8,9,10,11,12,13,14. Origanum ramonense Danin, (vernacular name: Suleimeyah (اسليمية)) has been used as a source of pharmaceutically active compounds and is an indigenous species native to sunny spots in the wilds of the Negev Desert, particularly in the Makhtesh Ramon area of Palestine19,21,22,23,24,25. Despite the extensive research on the Origanum genus, very few studies have been conducted on Origanum ramonense (Fig. 1A). Moreover, the few studies available are mainly focused on the antibacterial activities and identification of compounds in the extracted volatile oils, using gas chromatography26,27. In these studies, volatile oils compounds such as types of alcohols and mixes of hydrocarbons with major components being α-terpineol (41.53%)26 and carvacrol (84.6%)27 have been identified. Furthermore, some studies have also explored the bioactivity of the essential oils from Origanum ramonense Danin demonstrating its broad-spectrum antimicrobial effects against Staphylococcus aureus, S. epidermidis, Klebsiella pneumoniae and Enterobacter aerogenes27,28.
Metabolomics studies of medicinal plants provide an extremely effective and systematic approach for the comprehensive analysis of the plant metabolome29,30,31,32,33. The metabolomic methods not only allow for the analysis of metabolites and metabolic pathways but also help in identifying therapeutically significant compounds34,35. Although metabolomics utilizes several analytical platforms, mass spectrometry combined with gas chromatography (GC-MS)36, liquid chromatography (LC-MS)37, and nuclear magnetic resonance (NMR) spectroscopy are the most commonly used techniques38,39,40,41. Due to the diversity of metabolic structural classes and the limitations of respective techniques, it is highly recommended to employ several analytical tools to obtain a holistic metabolomic profile42,43,44. In addition to the limitations of different instruments, the variation in extraction methodologies, such as the technique, temperature, duration of extraction, and solvent system plays a crucial role in metabolic profiling45,46,47,48. The diverse chemical characteristics of metabolites also make it nearly impossible for a single solvent to extract all the metabolites. Along with instrumental and chemical metabolomics methods, the use of multivariate statistical analysis such as Principal Component Analysis (PCA), Hierarchical Cluster Analysis (HCA), and Partial Least Square-Discriminant Analysis (PLS-DA) facilitates the analysis of large sets of chemical data and are important for determining the functional relations between metabolites, comparing and summarizing the data42,49.
Thus, our investigation presents an enhanced approach by utilizing multiple solvents to explore the metabolic profile of a plant through both solid and liquid state NMR as well as GC-MS analysis, coupled with multivariate statistical analysis. In addition to profiling the metabolites, we have also evaluated the plant’s antioxidant capacity using DPPH and TPC (total phenolic content) assays50. To further understand the curative value of O. ramonense, the anticancer and antimicrobial properties of the extracts on two cancer cell lines and one normal cell line were also investigated. Aditionally, computational studies (docking) were also done to understand the anticancer and antiviral potential of the identified metabolites. When compared to the previous studies, the novelty of this research lies in its integrative approach where we combine comprehensive profiling with bioactivity and in-silico assessments to uncover the plant’s therapeutic potential.
Results
Untargeted qualitative metabolite profiling of Origanum ramonense plants using NMR
The use of nuclear magnetic resonance (NMR) spectroscopy for the analysis of the metabolite profile of plants is an effective and widely accepted tool due to its high reproducibility and versatility for analyzing a wide range of sample types51,52,53,54,55. Furthermore, it can also serve as a semi-quantitative tool, as the intensity of each signal in an NMR spectrum is directly related to its concentration56,57. This allows for the direct comparison of concentrations of all functional groups, eliminating the need for calibration curves for each component. More precisely, NMR represents the actual molar concentrations of metabolites found in a plant and can provide a quick overview of the entire plant metabolite composition and other natural products as well58. Recent research has also explored the role of NMR in determining functional groups and quantifying them in a wide range of natural products such as oil, natural gas, and plant extracts59,60. In our study, we have segmented the NMR spectra into different regions corresponding to specific functional groups. The integrated area under the curve of each divided region is directly proportional to the analyte concentration (Figs. 2 and 3 and Table S1)61.
The overlay of the 1H NMR spectra (Fig. 2) distinctly illustrates the differences in the metabolic profile of the O. ramonense when extracted with different solvents. The up-field regions (δ 4.4 to 0.5 ppm) of the NMR spectrum focusing on the methyl (CH3), methylene group (CH2) and methine group (CH) functional groups of the amino acids and other metabolites derived from carbohydrates, such as Glucose, Pyruvate, Lactate, Ribose62. The downfield region (δ 5–10 ppm) shows distinct patterns for each solvent, further supporting the role of solvent in influencing metabolite extraction (Figs. 2, S2 and S3). The role of solvent used is corroborated quantitatively by the box plot and the line curve (Fig. 3). From Fig. 3, we can see that the highest amino acid region is observed in the ethyl acetate (8.4%) extract followed by methanol/water (5%). Polysaccharides are the predominant functional group extracted by all solvents, especially prominent in the methanol (48.9%), water (45.9%), and methanol/water (44%) extracts. The carboxylic and carboxyl-rich alicyclic molecules (CRAM) region as well the aliphatic region are highest in the ethyl acetate extract whereas water has the highest percent of amides. The aromatic compounds play a decisive role in determining plant bioactivity and are comparatively higher in water (6.1%) and methanolic (5.7%) solvents than the other solvents63. Hence, by using multiple solvents we obtain a broader range of chemical profiles which is essential for comprehensive metabolite profiling.
A stack plot of the 1D 1H NMR spectra of Origanum ramonense plant extracts using five different solvents (i.e., (a) Ethyl acetate; (b) Methanol/water; (c) Dichloromethane /methanol; (d) Methanol; (e) Hot water).The inserted image is the magnified NMR Spectrum of the downfield Region (δ 6.0 to 10.0 ppm). All measures captured using NMR at 800 MHz resolution.
Furthermore, solid-state NMR eliminates the need for preparation and extraction steps that can sometimes lead to the loss or degradation of many metabolites, thus offering the advantage of analyzing a sample in its natural state52,53,54. In our study, we have used 13C NMR (solid-state) to quantify the various functional groups in the plant sample61,64,65. From Fig. 4, we observe that, as anticipated, the highest percentage of compounds are polysaccharides followed by aliphatic carbon groups. The plant leaves also have a substantial percentage (8.8%) of aromatic and phenolic compounds that will contribute significantly to their antioxidant and bioactive capacity.
Metabolite profiling of Origanum ramonense plants using GC-MS
The use of mass spectrometry aims to maximize the detected and identified number of metabolites present in a biological sample34,66. In the present study, we analyzed the plant extracts obtained using different solvents with varying polarity to obtain a comprehensive metabolic profile using gas chromatography coupled with mass spectrometry (Table S2). Figure 5A illustrates the total ion chromatogram of the plant extracts from a pooled sample. The metabolites identified from the chromatogram were statistically analyzed using principal component analysis to understand the variances in the data due to the use of solvents of varying polarity. In Fig. 5B, a clear distinction between metabolites obtained from polar and non-polar solvents can be observed, with the principal components one and two demonstrating a total variance of 86.9%. This is further observed in the VIP score plot (Fig. 5D) which highlights the top metabolites (VIP score > 1.3), indicating major differences between the extracts obtained from solvents of varying polarity. For instance, polar oxalic and citric acids have a much higher concentration in the hot water extract compared to the dichloromethane extract, whereas fat-soluble vitamins (such as alpha-tocopherol) are found at a higher concentration in the DCM/methanol sample compared to the polar solvent samples. Hence, multivariate data analysis involving multiple solvents not only gives an extensive number of metabolites but also aids in selecting the optimal solvent for extracting specific metabolites, based on the desired analytical outcomes. Similarly, the hierarchical clustering heatmap (Fig. 5C) where the most significant metabolites are represented helps us obtain a broader perspective on the metabolite composition and its variations across solvents. The clustering of the different metabolites highlights the similarities and differences between the plant extracts obtained using different solvents. For instance, certain plant organic acids (shikimic acid, oxalic acid, and tartaric acid) have a higher extraction yield in polar solvents (methanol/water and water) as compared to non-polar solvents. Thus, the statistical analysis highlights the importance of the solvent in the extraction of plant metabolites as well as the benefit of using multiple solvents of varying polarity to acquire a comprehensive profile when studying plant metabolites.
Figures S4 and 5E show results from enrichment analysis used to classify the different metabolites obtained through profiling. The bar diagram and the pie chart represent the chemical groups with the highest enrichment ratio (top 25) (hits = observed hits and expected = expected hits). From Fig. 55, we can see those phrenol lipids, acids, and their derivatives as well as fatty acyls that have the highest enrichment ratio as compared to other chemical classes. The bar diagram (Fig. S4) also helps us to classify the chemical groups with the highest number of metabolites (Table S3). By organizing metabolites into these important groups, we gain insights into their functional relevance and potential impact on biological processes.
(a) Total ion chromatogram of the metabolites obtained from GC-MS analysis of the O. ramonense plant using different solvents; (b) The PCA score plot of the O. ramonense plant extracted in hot water, methanol, and methanol/water, ethyl acetate, dichloromethane/methanol ; (c) Heat map of the O. ramonense plant depicting the different and similar metabolites obtained from the five different solvents; (d) VIP (Variable Importance in Projection) score chart of the most significant metabolites obtained from the five different solvents; (e) Enrichment analysis pie chart illustrating the proportion of each chemical group relative to the total number of metabolites identified by GC-MS analysis. The colors in the pie chart represent different chemical groups, highlighting the distribution within the total of metabolites.
Antioxidant activity and total phenolic content
Numerous bioactive substances with strong antioxidant activity are found in plants and there are numerous assays available to determine the antioxidant potential of a plant extract. For instance, in our study, we have used the radical scavenging assay (DPPH) and Folin–Ciocalteu (F–C) redox methodology to quantitate the antioxidant capacity and total phenolic content of the plant extracts obtained using multiple solvents. These techniques are quick, easy to use, and yield accurate results. For DPPH analysis, the drop in absorbance at 517 nm due to high decolorization of the DPPH solution in the presence of strong antioxidants is used to calculate the IC50 value, which is the concentration of the antioxidant needed to reduce the initial DPPH concentration by 50%. Thus, the lower the IC50 value the higher the radical scavenging activity by which the antioxidant potential is measured. The standard ascorbic acid curve verifies the instrument’s stability and method suitability (Fig. S5).
Here, the IC50 values are calculated from the graphs in (Fig. 6A,B, and S5) and the results are summarized in Table 1. From this table, we can see that the methanol/water extract displayed the lowest IC50 value (35.3), suggesting comparatively higher antioxidant capacity among the tested extracts. exhibit moderate antioxidant potential under the present assay conditions show moderate antioxidant potential based on the lowest IC50 value calculated from methanol/water extracts. These findings indicate that solvent polarity may influence extraction efficiency, as the combination of two polar solvents (methanol and water) appeared to yield an extract with enhanced radical-scavenging activity. This observation is supported by the Folin–Ciocalteu (F–C) assay, where a higher phenolic content was detected for the same extract. From the values in Table 1 it appears that the methanol/water extract contains the highest amount of phenol followed by the separate methanol and water extracts. The TPC and antioxidant potential of the plant extracts obtained from the different solvents are summarized in Fig. 7 using a bar chart showing a positive trend between phenolic content and antioxidant capacity, suggesting that phenolic compounds may contribute to the measured activity. However, these findings are preliminary and reflect only in-vitro chemical assays. Further mechanistic and in-vivo studies are needed to confirm the biological relevance and identify the specific compounds responsible for the observed effects.
(a) Dose-dependent DPPH (%) radical scavenging activity of O. ramonense plant extracts obtained using different solvents (hot water, methanol/water, methanol); (b) Dose-dependent DPPH (%) radical scavenging activity of O. ramonense plant extracts obtained using different solvents (ethyl acetate and dichloromethane/methanol) ; (c) Dose-dependent standard gallic acid reference curve used to compute the quantity of phenolic content in the plant extracts (mg of gallic acid equivalent (GAE)/gram of dry weight plant). The Pearson correlation coefficients (r) obtained from the graphs are greater than 0.9 for all solvents. The samples were analyzed in triplicates.
MTT assay and In-vitro antibacterial activity
For the MTT assay, crude extracts were tested at concentrations of 1, 5, 10, 25, 50, 100, and 200 µg/mL on MCF-7, HeLa, and HEK-293 cells, with all experiments performed in triplicate. IC50 values were calculated using nonlinear regression analysis in GraphPad Prism 9, and statistical significance was determined using one-way ANOVA followed by Tukey’s post-hoc test, with p < 0.05 considered significant. For the antibacterial assay, extracts were applied at 20 µg/disc against Staphylococcus aureus and Streptococcus pneumoniae, with measurements performed in triplicate. Data are reported as mean ± standard deviation. The MTT in-vitro cell proliferation assay is a commonly employed technique for assessing cell growth and viability and understanding whole-cell cytotoxicity67. It is also used for the initial evaluation of the anticancer potential of natural materials and extracts from natural products. According to the cytotoxicity criteria for crude extracts established by the U.S. National Cancer Institute (NCI) an IC50 value of less than 20 µg/mL in the preliminary assay indicates strong anticancer potential. Thus, this preliminary cytotoxicity assay provides valuable insights into the anticancer properties of a plant, indicating which extract is most suitable for isolating metabolites with promising anticancer activity68.
The MTT assay is a highly dependable, colorimetric assay that can be easily conducted on various cell lines69. Moreover, plant metabolites are known to initiate apoptosis in cancerous cells, so using the MTT test to compute the IC50 values allows us to assess the anticancer effects of crude extracts of the O. ramonense plant on MCF-7 and HeLa cell lines. Table 2 shows that the ethyl acetate, methanol/water, and water extracts exhibit significant activity against the MCF-7 cell line with an IC50 value of 11,10, and 17 µg/mL respectively. However, the same crude extracts did not show strong anticancer activity against the HeLa cell line. Other extracts, such as crude extracts from DCM/methanol and methanol alone, showed no significant activity against any of the cancer cell lines. Furthermore, and of great importance, none of the crude extracts showed any cytotoxicity against the reference normal HeK 293 (human embryonic kidney) cell line, thus indicating a very good safety profile of all the plant extracts. Interestingly, the crude extracts exhibited a stronger cytotoxic effect on the MCF-7 breast cancer cells compared to the HeLa cervical cancer line. This differential sensitivity may reflect cell-type–specific differences in compound uptake, metabolism, or target protein expression. MCF-7 cells, which are estrogen receptor–positive, are known to respond to polyphenolic and terpenoid compounds that influence oxidative stress and mitochondrial function. The weaker activity in HeLa cells could indicate lower affinity for these molecular targets or enhanced resistance mechanisms. These findings suggest a potential degree of selectivity toward breast cancer–related pathways, although further mechanistic and apoptosis-based studies are warranted to confirm these effects and clarify the underlying molecular basis.
It has already been established that the volatile oils of Origanum species as well as O. ramonense Danin possess antibacterial properties27,68. In the present study, we investigated the antibacterial activity of crude extracts using the agar disc diffusion method, with ampicillin as the positive control. Streptococcus pneumoniae and Staphylococcus aureus are leading causes of community-acquired and hospital-acquired pneumonia, respectively, and both pathogens exhibit strains that are highly resistant to penicillin and other antibiotics, resulting in a significant number of fatalities each year due to infections caused by these organisms. Thus, the emergence and prevalence of antibiotic resistance have contributed to the intensified search for new compounds with which to combat these infections, many of which are sourced from plants that have a long history of traditional use to combat bacterial infections.
In our study, we measured the diameter (in mm) of the zone of inhibition using the agar disc diffusion method. Overall results are presented in Fig. 8A, where we see that ethyl acetate, water, and methanol/water crude extracts demonstrate the highest diameters of inhibition at 29 mm, 27 mm, and 25 mm, respectively, against Staphylococcus aureus, and 27 mm, 22 mm, and 24 mm, respectively, against Streptococcus pneumoniae. Thus, by order of efficiency, ethyl acetate, methanol/water, and water extracts exhibit the most effective antimicrobial activity against both gram-positive bacteria. Figure 8B,C show images of discs on which measurements were carried out.
(a) Antimicrobial activity of the different extracts according to the diameters (mm) of the zone of inhibition; (b) Agar disc showing the antimicrobial activities of metabolites from methanol/water and ethyl acetate extracts by inhibition zones (mm) on Staphylococcus aureus. (c) Agar disc showing antimicrobial activity of metabolites from methanol/water and ethyl acetate extracts by inhibition zones (mm) on Streptococcus pneumoniae.
Using the mentioned variety of extracts and assays allows us to infer the antibiotic potential of O. ramonense and identify the most effective extraction methods for isolating metabolites with antibiotic properties. Based on the results from both the MTT assay and the antimicrobial assay, we may conclude that ethyl acetate and methanol/water are the preferred solvents for extracting bioactive metabolites. Results are summarized in Table 2 below.
In-silico docking analysis
The comprehensive metabolomic profiling using GC-MS and NMR has helped us identify extensive list of metabolites from which 12 molecules have been chosen to evaluate the anti-cancer potency of the plant and to test their anti-virus inhibition using molecular docking. In Table 3, presented the docking scores obtained against the cancer targets with RMSD-refine value. The values were in the range of − 4.0 to 7.58 kcal/mol which tested the Alpha-tocopherol acetate, Alpha-tocopherol and Oleanolic acid and also demonstrated substantial binding to both selected cancer targets. Comparing to the in-vitro IC50 values, the efficiency of the extracted molecules showed better inhibition toward MCF-7 cells than HeLa cells which is aligned as well to the computation calculation. The mentioned compounds are practically insoluble or poorly dissolved in water and its miscible with organic solvents thus this explained the effectiveness of the ethyl acetate solvent extracted crude in this analysis. Indeed, the tested ligands were found to be bonded to several amino acid residues by different bonds as hydrogen bond, van-der Waals and pi doner/acceptor hydrogen bond as presented in 2D and 3D for Alpha-tocopherol acetate as a best molecule with highest interactions, Table 4.
The free energy scores obtained from docking studies of the investigated compounds toward the different targets of covid-19 protein are illusterated in Table 5.
There are many standard antiviral drugs have which have shown practical potency towards SARS-CoV- such as Remdesivir, Nelfinavir and Favipiravir70,71,72. Thus, we used them as benchmark to test their performance by docking against the same site targets and same protocol. Both Remdesivir, Nelfinavir showed the best results, Table S7, and Nelfinavir has also been chosen in this study as positive control.
Comparing to Nelfinavir, binding energy of three compounds, Alpha-tocopherol acetate, Alpha-tocopherol, linalyl acetate exhibited moderate to srong binding potential with all receptors. On another hand, thymol, vanillic acid, protocatechuic acid, and caffeic acid showed notable binding affinity against the spike glycoprotein. Moreover, the values of RMSD-refine were in the rang of 0.8 to 1.98 which were acceptable.
The docking images for some of these molecules against spike glycoprotein molecules in 2D and 3D are showed in Table S4. The most interested interactions were with important amino acids residues spike glycoprotein (closed state) (6Vxx) as Asparagine (ASP-867), Threonine (THR- 778), Glutamine (GLN- 774) and Glycine (GLY-1059) through hydrogen bonding. Other interaction such as Vander Waal forces, alkyl and pi- alkyl bindings were formed with Phenylalanine (PHE-782), Proline (PRO-863) and Isoleucine (ILE- 870) amino acids. Even though all tested O. ramonense compounds could interact with the spike glycoprotein but oleanolic acid, (−)-Borneol, caryophyllene alpha-oxide and beta-caryophyllene showed low binding affinity when compared to the other metabolites.
For S2 subunit (6LXT) results, Alpha-tocopherol acetate, alpha-tocopherol, oleanolic, acid, vanillin acid and caffeic acid have the best scores among the other molecules. Moreover, in-silico results against Mpro showed Alpha-tocopherol acetate, Alpha-tocopherol, oleanolic, acid vanillin acid, linalyl and caffeic acid have strong interaction. This interaction for some metabolites are shown in Tables S5 and S6. The Vander Waal forces, alkyl and pi- alkyl bindings interactions were found in both Mpro and S2 subunit functionally reverent amino residue such as Histidine (HIS-41), Cysteine (CYS-145), Threonine (THR-190), Serine (SER-939), Glutamine (GLU-935) and Leucine (LEU-189) with phenyl ring in the ligand, respectively. In Fig. 9 we have summarized the bioactive molecules and their viral target in the SARS-CoV virus.
Discussion
The main aim of the study reported here was to provide a comprehensive overview of the chemical composition of O. ramonense using different solvents for extraction of compounds to identify the diversity of bioactive metabolites that may be derived from this plant and assess the impact of solvent on the extraction results. Earlier studies have focused on identifying essential oils and antibacterial potential of O. ramonense plants. In contrast, we have taken a more comphensivve approach by combining different analytical techniques and assays to preliminary profile a wide spectrum of metabolites (total 56 metabolites) using multi-solvent extraction methodology and also assess its bioactivity. Overall, the liquid-state NMR results suggest that the metabolic profile of O. ramonense is highly solvent-dependent, with different solvents extracting different classes of metabolites based on their polarity. Moreover, results from both liquid and solid-state NMR analyses indicate that the polysaccharide region dominates the spectra, likely due to the abundance of cellulose, the primary structural fiber in plants. Additionally, elevated signals corresponding to carboxylic acids, phenolic, and aromatic compounds were particularly prominent in the methanol/water and water extracts. This was further supported by the GC-MS analysis where we identified a diverse range of metabolites with known therapeutic effects, such as flavonoids, alkaloids, and other phenolic compounds, which supports the assumptions about the plant’s therapeutic potential. One notable compound identified in our study of O. ramonense, is vanillic acid (VA) which has been widely studied for its bioactive properties. VA has demonstrated anti-inflammatory, antimicrobial, anti-venom, hepatoprotective, and cardioprotective activities73. Beta-sitosterol, which belongs to the sterol class of compounds, in our study primarily extracted using ethyl acetate (Fig. 5C), has also been shown in other studies to exert antibacterial activity, particularly against bacterial strains such as Salmonella typhi, Staphylococcus aureus, and Escherichia coli74,75. These results from other studies are validated in our experimental studies where the ethyl acetate extracts demonstrated significant antibacterial activity and moderate anticancer potential (Fig. 7; Table 2). From both NMR and GC-MS data, it is evident that carbohydrates, including D-glucose and other simple sugars, are the largest groups of chemical constituents of Origanum ramonense. These carbohydrates not only serve as the primary source of energy for the tricarboxylic acid cycle (TCA cycle) but also form the building blocks for complex carbohydrates, such as glycosphingolipids, which play a crucial role in cell-cell interactions and immune responses.
Bioactivity testing was conducted to assess the antioxidant and antibacterial potential of the crude extracts obtained from different solvents using ABTS scavenging activity assay, MITT assay, and agar disc diffusion. The results show that ethyl acetate crude extract does not exhibit strong antioxidant potential which may be due to low phenol content but this crude extract still demonstrated significant antibacterial and anticancer properties. This may be attributed to the ability of flavonoids to inhibit cancer cells through the mutilation of cancerous DNA and the stimulation of apoptosis-related enzymes as well as inhibition of the growth of gram-positive bacteria, rather than contributing directly to the production of reactive oxygen species (ROS) which are essential for antioxidant activity. Similarly, while the methanol extract exhibited good antioxidant potential, it did not demonstrate very strong anticancer or antimicrobial activity. This limited anticancer and antimicrobial effectiveness of methanol extract may be due to synergistic effects within complex metabolic processes that are not fully captured by simple in-vitro bioassays.
Previous Insilico as well as invitro studies have examined the anticancer potential of caffeic acid across various cancer types, including breast cancer. For instance, Rezaei-Seresht et al.‘s (2019) study focused on invitro as well as docking studies of caffeic acid on Erα .They reported relatively strong binding free energy scores of − 4.47 kcal/mol for caffeic acid on Erα receptor which confirms its therapeutic potential as anticancer agents76 .Additionally, another study in 2021 reported a free energy binding score of − 6.6 kcal/mol of caffeic acid and p-coumaric acid with cytochrome p450 aromatase enzyme. Since aromatase inhibitors are generally used as an adjuvant therapy for postmenopausal breast cancer patients, hence this docking study further reinforces the potential of these metabolites as anticancer agents77. Furthermore, previous docking studied have already assessed the antibacterial potential of some of our identified metabolites .For instance, a research done in 2022 not only used molecular docking but also molecular dynamics simulations to understand the interaction of thymol with multiple bacterial species (Candida albicans (C. albicans), Staphylococcus aureus (S. aureus), and Escherichia coli (E. coli) where they observed the highest binding energy of − 24.73 kcal/mol with S. aureus highlighting its strong antibacterial potential78. Another in-silico and docking study not only highlighted the role of vanillic acid as anti-cancer but also as an antimicrobial agent .In addition, positive DME/TOPKAT predictions also established its use as a therapeutic for fighting cancer and bacterial infections79. The MMT analysis using MCF-7 cells than HeLa cells showed moderate to strong inhibition of the crude extraction of water/methanol and ethyl acetate solvent. We utilized molecular docking programme to explain and identify the most bioactive compound inhibition. Three molecules presented high interaction toward the investigated targets which are Alpha-tocopherol acetate, Alpha-tocopherol and Oleanolic acid.
Based on previous studies, which have shown the potential of polyphenols and alkaloids to combat COVID-1980,81,82, in-silico docking has been used to estimate the efficacy of the metabolites compounds in this study against SARS-COV spike protein. Since the SARS-CoV virus enters the human cells through its spike protein which binds to the human angiotensin-converting enzyme 2 (ACE2) receptor and thus facilitates the fusion with the target membrane82,83. Therefore, spike glycoprotein (closed state) (6Vxx) and S2 subunit(6LXT) are considered a potential target for viral fusion inhibition. In this study, out of 12 O. ramonense compounds, four of them exhibited significant molecular docking score (ranging between − 8.16654 to − 5.48967 Kcal/mol) against the investigated targets. Interestingly, Alpha-tocopherol acetate showed greater score than nelfinavir against S2 subunit (− 5.8517 Kcal/mol) and almost similar with spike glycoprotein and Mpro. Moreover, Alpha-tocopherol and oleanolic acid also exhibited strong binding interaction to Mpro and S2 subunit proteins. Furthermore, these molecules bind successfully with Mpro(6lu7) which is present in the membrane protein and has an important role in the replication process80. Thus, from the chemical point, it can be inferred that molecules with s hydroxyl and carbonyl functional groups could target different signaling pathways in different stage of cell transformation which in turn enhances their binding potential84. Future studies can validate these preliminary computational findings through in-vitro or in-vivo assays to more conclusively determine the antiviral efficacy of the crude plant extract.
In Fig. 10, below, we identify the metabolites that most likely are responsible for the observed bioactivity of the extracts by correlating the identified metabolites with the results from the bioassays. Among the metabolites, the phenols and their derivatives exhibit different bioactivity such as anticancer, antimicrobial, and antioxidant activity. These compounds mostly work by lowering oxidative stress, altering signaling pathways, and causing apoptosis in cancer cells. For example, caffeic acid prevents abnormal cell proliferation by interfering with nuclear factor-kappa B (NF–kB) thus supporting apoptosis85,86. Fatty acids (Fig. 10, Groups B and C) such as caprylic acid, and palmitic acid show diverse bioactivity, including antioxidant and antimicrobial properties. The chemical structures of fatty acids play a crucial role in the metabolic process where they interact effectively with biological membranes in manners that disrupt the pathogen integrity, thus contributing to their therapeutic potential.
Materials and methods
Collection and preparation of extraction solvents
The plant was originally transferred from the Negev desert of south Palestine, and then grown in Baninaim of the West Bank, Palestine. A botanical specimen is present in the Al-Quds University Herbarium with voucher number (AR-AQUB 2022). In July 2023, the shoots and leaves of the plant were collected and air dried in shade. The air-dried plant material was then transferred to the laboratory and pulverized using a mortar and pestle and liquid nitrogen. The powdered plant samples were stored in airtight containers at − 80 °C until analyzed.
Extractions were prepared using five different solvents, i.e., water (HPLC grade, VWR chemicals), methanol, methanol/water (ratio of 1:1(v/v), VWR chemicals), dichloromethane/methanol (ratio of 2:1(v/v), Honeywell Riedel-de Haen Germany), and ethyl acetate (VWR Chemicals, PA, USA).
Preparation of crude extracts
The powdered plants were aliquoted (25 mg for GC-MS; 80 mg for NMR) in replicates along with extraction beads (Fisher Scientific/Glass 4 mm) and 2 mL of extraction solvent followed by 5 min of high-speed vortex. The water extraction tubes were maintained at a high temperature (80 °C) and extracted for four hours whereas the four other solvents were extracted overnight (~ 24 h) at room temperature on a homogenizer with a maximum of 1400 RPM. All the extracts were further sonicated and centrifuged (10 min, 1200 rpm) to obtain the supernatant (crude extract). This process was repeated a few times to obtain clear crude extracts and samples stored at − 80 °C until analyzed.
Sample preparation and instrumentation for NMR analysis
Liquid-state NMR analysis
The NMR samples were prepared by drying 1.5 mL of crude extracts overnight in a speed vacuum. The dried extracts were further dissolved in 600 µL of deuterium oxide (purity 99.9 atom % D, Sigma-Aldrich) and vortexed at high speed followed by centrifugation at room temperature (5 min 14,000× g). The supernatant was then transferred to 5 mm NMR tubes, and the spectrum was recorded using Bruker 800 MHz AVANACE NEO NMR spectrometer at 298k with Bruker TCI (cryogenic probe (BrukerBioSpin, Rheinstetten, Germany). The ZGESP (Zero-Gradient Exponential-Sweep Pulse) pulse program from the Bruker library with 128 scans and 8 dummy scans with 5 s relaxation delay and 15.6 ppm sweep width with acquisition time of 2.6 s was used to suppress the water peak observed at 4.7 ppm. Using Topspin (4.0.7) the spectrum was processed by correcting the baseline, amplifying the FID signals by line broadening of 1 Hz, and adjusting the chemical shifts by setting the TMS (internal standard) peak at 0 ppm. The area under the curve was integrated by dividing the NMR spectrum into multiple regions based on the presence of a specific functional group at that frequency.
Solid-state NMR analysis
The powdered plant samples were evenly packed into the 4 mm rotor sealed with a cap and analyzed using Bruker 400 MHz AVANACE III spectrometer with MAS Bruker Probe (BrukerBioSpin, Rheinstetten, Germany). The 13C NMR spectrum was recorded using the CP (cross polarization) pulse program from the Bruker library at the 14 kHz spinning rate with more than 24k scans, delay time (D1) of 5 s, and spectral width of 405 ppm 87. The data were processed by correcting the baseline and adjusting the phase. The area under the curve was further integrated by splitting the spectrum into 7 regions according to the presence of a particular functional group in that area88.
Sample preparation and instrumentation for GC-MS analysis
A Thermo Scientific Orbitrap Exploris GC 240, which has a maximum resolving power of 240,000 (at m/z 200 FWHM), was used for the analysis of the primary metabolites. Sample introduction was performed using the Thermo Scientific™ TriPlus™ RSH auto-sampler, and chromatographic separation of the gas-phase chemical components was achieved using the Thermo Scientific™ TRACE™ 1310 Gas Chromatograph equipped with Thermo Scientific™ Trace GOLD™ TG-5SilMS 30 m × 0.25 mm i.d. × 0.25 μm column. The Orbitrap Exploris GC was tuned and calibrated using PFTBA to achieve mass accuracy of < 1.0 ppm. The Orbitrap Exploris 240 mass spectrometer operated in electron ionization (EI) mode was set at 300 °C, and the electron energy was set to 70 eV with an emission current of 50 µA. The acquisition mode was set to full scan with a scan range of 35–700 Da and an orbitrap resolution of 60,000 (FWHM, measured at m/z 200). The AGC target was set to standard, and the maximum injection time was set to auto mode. The data acquisition was lock-mass corrected using GC column bleed siloxane masse of m/z 207.The Trace 1310 GC was operated with an injection volume of 1 µL of sample injected using a 10 µL syringe into a single gooseneck with glass wool Thermo Scientific™ Liner GOLD. The inlet mode was set to Split mode with a split flow of 40 mL/min and a purge flow of 5 mL/min. The helium carrier rate was set to 1.2 mL/min. The oven temperature was maintained initially at 70 °C for 2 min and increased to 220 °C at a rate of 8 °C/min, then increased to 325 °C at a rate of 16 °C/min and was held for 10 min.
The GC-MS samples were prepared by following the protocol of Salem et al. with a few modifications89. All the extracted samples were derivatized with BSTFA (O-bis (trimethyl-silyl) trifluoroacetamide (Sigma-Aldrich, USA) spiked with a 10 µg/mL stock solution C7-C40 hydrocarbon (saturated alkanes standard, Supelco, 49452-U). The quality control sample was prepared by making a pooled sample consisting of all the extracted samples. In addition, the sample vials were analyzed in a randomized order to reduce bias in the results. The retention index (RI) of chemical components was putatively identified using the Mass Spectral Library (NIST2020) and the Thermo Scientific™ Orbitrap™ GC-MS HRAM Metabolomics Library.
Statistical and multivariate analysis of GC-MS
The raw data obtained from the GC-MS analysis were curated using Compound Discoverer 3.3 software (Thermo Scientific, US) for chemometric assessment of the EI data (spectral deconvolution, compound identification, and multivariate statistical analysis). The data were processed using the workflow for untargeted metabolomics using multivariate statistical analysis (principal component analysis (PCA), and volcano plot (v-plot) to select the significant features, defined by their m/z retention time, contributing to the group differences. The chromatographic peaks were then deconvoluted, aligned, and putatively identified using mass spectral library match (NIST20 nominal mass library and Orbitrap GC-MS HRAM Metabolomics Library). Further comprehensive and integrative metabolomics data analysis was carried out using the MetaboAnalyst 6.0 online (https://www.metaboanalyst.ca). The discovered metabolite data were subjected to heatmap clustering analysis (HCA), principal component analysis (PCA), and VIP score analysis.
Sample preparation for 2,2-diphenyl-1-picrylhydrazyl (DPPH) and Folin–Ciocalteu total phenolic assay
The plant crude extracts were dried overnight in Eppendorf tubes using a speed vacuum, the yield was calculated for each sample, and the dried extracts were dissolved in water or methanol.
The powdered DPPH (Thermofisher Scientific) was dissolved in methanol to obtain a concentration of 0.2mM (with absorbance < 1). The standard reference, ascorbic acid (Sigma Aldrich), was prepared in methanol at several different concentrations (2.5 µg/mL to 15 µg/mL). The total reaction mixture of 200 µL for each plate (100 μL standard/sample/solvent and 100uL DPPH) was added in the 96-well plate and incubated in the dark for 1 h under constant shaking. The absorbance was recorded immediately after incubation using a plate reader at 517 nm. The total phenolic content was estimated using the Folin–Ciocalteu technique. The diluted plant extracts (20 µL) were mixed with 10% Folin–Ciocalteu reagent (100 µL) prepared in methanol and incubated for 5 min in the dark. Thereafter, 7.5% Na 2CO3 (80 µL) was added to the reaction well. This was again incubated for 1 h before measuring the absorbance at 750 nm. Gallic acid (Sigma Aldrich) of varying concentrations (25–700 µg/mL) was used as the standard. All the samples were prepared in triplicates. The calculation of the total phenolic content was done following the methodology used by Molole, G. et al.90.
Sample preparation for the MTT assay and in-vitro antibacterial activity
The viability of cultured cells was assessed by enzymatic reduction of the tetrazolium dye MTT ((3-(4, 5-dimethylthiazolyl-2)-2, 5-diphenyltetrazolium bromide) to formazan. To assess anticancer activity, three cell lines were used: two tumor cell lines (MCF-7, a human breast cancer cell line; and HeLa, a malignant cervical tumor cell line), and one normal cell line (HEK293, human embryonic kidney cells). The three cell lines were cultured in Dulbecco-modified Eagle’s medium (DMEM) supplemented with 0.2% sodium bicarbonate and 10% fetal bovine serum. The cells were kept at 37 °C in a 5% CO2-95% environment with high humidity. Cell viability was evaluated using the trypan blue dye exclusion test, as previously described91,92. This investigation used batches of cells with over 98% vitality, measured by the MTT assay as previously published38,93.
Briefly, 10,000 cells from each cell line were plated in 96-well culture plates and allowed to adhere for 24 h in a CO2 incubator at 37 °C. After exposure to the different concentrations of each of the five different crude extracts, MTT (5 mg/mL of stock PBS) was added (10 µL/well of 100 µL of cell suspension) to each well, and the plates were incubated further for 4 h in a CO2 incubator. Then, the supernatant was discarded, and 200 µL of DMSO was added to each well and mixed gently. The developed color was read at 550 nm in an Evolution 201 reader (Thermo Scientific, Waltham, MA, USA). Untreated control sets were also run under identical conditions. All the values were corrected for background absorbance. The survivability percentage x100% was calculated using (ODt/ODc), where ODc denotes the density of untreated cells and ODt signifies the density of wells treated with the test compound (crude extracts). By graphing the association between the number of cells that survived and the quantities of compounds (crude extracts), survival curves for each cancer cell line and the normal cell line following treatment with the specified isolated compounds were constructed. Using concentration chart pad Prism software, the 50% inhibitory concentration (IC50) was determined from charts of the dose response curve for all (San Diego, CA, USA).
The antibacterial activities of all extracted compounds were evaluated against pathogenic strains by applying the agar disc diffusion method94. The bacterial pathogens used in this study were Staphylococcus aureus and Streptococcus pneumoniae (gram-positive bacteria). Each bacterial strain was cultured onto a Muller–Hinton agar (MHA) plate and incubated for 18–24 h at 35 °C. All the crude extracts were prepared by dissolving 20 mg of each extract in 1mL of DMSO. Thus, DMSO was used as a negative control for all the samples examined and ampicillin was used as the positive control. A bacterial culture (which was adjusted to McFarland 0.5 standard solution (1.5 × 108 CFU/mL)) was used to lawn Hinton agar plates using a sterile swab. Paper discs with 5 mm diameters were impregnated individually with a constant amount (100 µg/mL) of each of the extracts. The antibacterial activity was determined by measuring the diameter of the zone of inhibition and comparing it with that of the positive control (ampicillin)38. The test assay was assessed twice, and no inhibition zone was found for the DMSO sample.
Methodology for in-silico docking studies
Origanum ramonense plant extract has various bioactive chemical molecules and have been tested as antimicrobial, anticancer and antieczemic inhibitors95,96,97,98. Thus, we have chosen 12 molecules to test their anti-cancer and anti-virus inhibition using molecular docking. This approach aimed to estimate the responsible bioactive molecules among the investigated compound for the bioactivities observed in the in-vitro experiments to add a novelty to this study and have a good impact to the scientific community by studying the viral potency of this plant. Thus, we have chosen 12 molecules to test their potency as anti-cancer and anti-virus inhibition using molecular docking. For the cancer study, cancer proteins ID = 1hk7 and 6i2i which presented MCF-7, a human breast cancer cell line; and HeLa, a malignant cervical tumor cell line, respectively. Here, three important drug targets of SARS-CoV, Mpro (ID = 6LU7), spike glycoprotein (closed) (ID = 6VWW), and S2 subunit (ID = 6LXT) have been subjected to the study using Nelfinavir as a reference92,94. Since, spike glycoprotein protein plays an important role in viral entry hence it acts as a key antigen for scientist to develop drug targets and vaccines. Another drug target, S2 subunit spike, which is the one that composes the main S spike also mediates the viral cell membrane fusion by forming a six-helical bundle via the two-heptad repeat domain99. Membrane proteins (Mpro) the richest viral structural protein and has a dominant role in virus assembly and morphogenesis.
The selected proteins and targets were downloaded from protein data bank (PDB), discovery Studio 2024 visualizer was used to clean the macromolecules from water, ligand compound and unwanted interaction and then saved as pdb files. Using AutoDock tools, the polar hydrogen and charges (Gasteiger and Koll-man) were added to fabricated files then saved as PDBQT format. Molecular docking studied was carried out using AutoDock Vina 4.0 and with the Lamarckian Gentic Algoirthm (LGA). The extracted files were visualized using Discovery Studio 2024 to present and study the interaction results of the ligand and the receptor as 2D and 3D figures.
Data availability
Data will be made available on requests from the corresponding authors.
References
Bennici, G. et al. Medicinal effects of ephedra foeminea aqueous extracts: metabolomic characterization, biological evaluation, and molecular Docking. PLoS One. 20 (7), e0328995 (2025).
Nageeb, A. et al. Comparison of Artemisia annua bioactivities between traditional medicine and chemical extracts. Curr. Bioact. Compd. 9 (4), 324–332 (2013).
Chaachouay, N. & Zidane, L. Plant-derived natural products: a source for drug discovery and development. Drugs Drug Candidates. 3 (1), 184–207 (2024).
Gurib-Fakim, A. Medicinal plants: traditions of yesterday and drugs of tomorrow. Mol. Aspects Med. 27 (1), 1–93 (2006).
Srivastava, A. K. Significance of Medicinal Plants in Human life, in Synthesis of Medicinal Agents from Plants, 1–24 (Elsevier, 2018).
Baranauskaitė, J., Liobikienė, G. & Bernatonienė, J. The Influence of different oregano species on the antioxidant activity of carvacrol and Rosmarinic acid. In International Conference on Research & Innovation in Computer, Electronics and Manufacturing Engineering (RICEME-17). International Conference on Chemical, Agricultural, Biological and Health Sciences (CABHS-) & International Conference on Civil, Disaster Management and Environmental Sciences (CDMES-17): February 2–3, 2017, Bali (Indonesia)/Editors: Lyubichankovskiy Sergey, Koryun Atoyan, Koorosh Gharehbaghi; Organised by: Excellence in Research and Innovation. Higher Education and Innovation Group. Bali:[sn], 2017. 2017. 2017. (2017).
Sharifi-Rad, M. et al. Phytochemical constituents, biological activities, and health‐promoting effects of the genus Origanum. Phytother. Res. 35 (1), 95–121 (2021).
Özkan, A. & Erdoğan, A. A comparative evaluation of antioxidant and anticancer activity of essential oil from Origanum onites (Lamiaceae) and its two major phenolic components. Turk. J. Biol. 35 (6), 735–742 (2011).
Gutiérrez-Grijalva, E. P. et al. Oregano as a potential source of antidiabetic agents. J. Food Biochem. 46 (12), e14388 (2022).
Tripathy, B. et al. Evaluation of anti-diabetic and anti-hyperlipidemic activities of ethanolic leaf extract of Origanum Majorana in streptozotocin induced diabetic rats. Int. J. Pharm. Sci. Res. 9, 1529–1536 (2018).
Patrignani, F. et al. Lamiaceae in the treatment of cardiovascular diseases. Front. Biosci. 26 (4), 612–643 (2021).
Jaradat, N. et al. Anti-lipase potential of the organic and aqueous extracts of ten traditional edible and medicinal plants in Palestine; a comparison study with Orlistat. Medicines 4 (4), 89 (2017).
Avola, R. et al. Oregano (Origanum vulgare L.) essential oil provides anti-inflammatory activity and facilitates wound healing in a human keratinocytes cell model. Food Chem. Toxicol. 144, 111586 (2020).
Hussain, A. I. et al. Composition, antioxidant and chemotherapeutic properties of the essential oils from two Origanum species growing in Pakistan. Revista Brasileira De Farmacognosia. 21, 943–952 (2011).
Marrelli, M., Statti, G. A. & Conforti, F. Origanum spp.: an update of their chemical and biological profiles. Phytochem. Rev. 17, 873–888 (2018).
Ferreira, M. P. et al. A traditional elder’s anti-aging cornucopia of North American plants. In Foods and Dietary Supplements in the Prevention and Treatment of Disease in Older Adults, 3–11 (Elsevier, 2015).
More, G. K. et al. Metabolomic profile of medicinal plants with anti-RVFV activity. Heliyon. 8(2). (2022).
Al-Nemi, R. et al. Comprehensive metabolomics profiling and bioactivity study of lycium Shawii (Awsaj) extracts with particular emphasis on potential Anti-Malarial properties. Metabolites 15 (2), 84 (2025).
Ward, D. & Olsvig-Whittaker, L. Plant species diversity at the junction of two desert biogeographic zones. Biodivers. Lett. 172–185 (1993).
Soltani, S. et al. A review of the phytochemistry and antimicrobial properties of Origanum vulgare L. and subspecies. Iran. J. Pharm. Res. IJPR. 20 (2), 268 (2021).
Della Pepa, T. et al. Antimicrobial and phytotoxic activity of Origanum heracleoticum and O. majorana essential oils growing in Cilento (Southern Italy). Molecules 24 (14), 2576 (2019).
Baser, K. H. C. The Turkish Origanum species. Oregano Genera Origanum Lippia. 109, 109–126 (2002).
Dudai, N. & Yaniv, Z. Endemic aromatic medicinal plants in the holy land vicinity. In Medicinal and Aromatic Plants of the Middle-East, 37–58 (2014).
Danin, A. Flora and vegetation of Israel and adjacent areas. Zoogeography Isr. 30, 251–276 (1988).
DANIN, A. Desert rocks–a habitat which supports many species that were new to science in the last 40 years. Turk. J. Bot. 32 (6), 459–464 (2008).
Danin, A. et al. Essential oil composition of Origanum Ramonense Danin leaves from Israel. J. Essent. Oil Res. 9 (4), 411–417 (1997).
Qaralleh, H. N. Chemical composition and antibacterial activity of Origanum Ramonense essential oil on the Î2-lactamase and extended-spectrum Î2-lactamase urinary tract isolates. III Bangladesh J. Pharmacol. 13 (3), 280–286 (2018).
Bassanetti, I. et al. Investigation of antibacterial activity of new classes of essential oils derivatives. Food Control. 73, 606–612 (2017).
Kahfi, J. et al. Untargeted metabolomics and in Silico screening of sisymbrium officinale: identification of flavonoid glycosides as potential Anti-inflammatory agents. J. Proteome Res. 24 (8), 3943–3960 (2025).
Waris, M. et al. Metabolomics analysis insight into medicinal plant science. TRAC Trends Anal. Chem. 157, 116795 (2022).
Sharma, B. & Yadav, D. K. Metabolomics and network Pharmacology in the exploration of the multi-targeted therapeutic approach of traditional medicinal plants. Plants 11 (23), 3243 (2022).
Xiao, Q. et al. Plant metabolomics: a new strategy and tool for quality evaluation of Chinese medicinal materials. Chin. Med. 17 (1), 45 (2022).
Singh, U. et al. Untargeted metabolic profiling of zygophyllum coccineum plant near the red sea for phytochemical investigation by GC-MS, LC-MS, and NMR. J. Saudi Chem. Soc. 29 (1), 1–23 (2025).
Hill, C. B. & Roessner, U. Metabolic profiling of plants by GC–MS. In The Handbook of Plant Metabolomics, 1–23 (2013).
Rambla, J. L. et al. Metabolomic profiling of plant tissues. In Plant Functional Genomics: Methods and Protocols, 221–235 (2015).
Paul, A. & Das, S. Gas chromatography mass spectrometry based metabolomic investigation on five different rice cutivars (Oryza sativa L.) under different induced cadmium stress. Food Chem. Adv. 2, 100175 (2023).
Sawada, Y. & Hirai, M. Y. Integrated LC-MS/MS system for plant metabolomics. Comput. Struct. Biotechnol. J. 4 (5), e201301011 (2013).
Alsuhaymi, S. et al. Untargeted metabolomics analysis of four date palm (Phoenix dactylifera L.) cultivars using MS and NMR. Nat. Prod. Bioprospecting. 13 (1), 44 (2023).
Emwas, A. H. M. et al. You are what you eat: application of metabolomics approaches to advance nutrition research. Foods 10 (6), 1249 (2021).
Heyman, H. M. & Meyer, J. J. M. NMR-based metabolomics as a quality control tool for herbal products. South. Afr. J. Bot. 82, 21–32 (2012).
Kim, H. K., Choi, Y. H. & Verpoorte, R. NMR-based plant metabolomics: where do we stand, where do we go? Trends Biotechnol. 29 (6), 267–275 (2011).
Teo, C. C. et al. Metabolomics analysis of major metabolites in medicinal herbs. Anal. Methods. 3 (12), 2898–2908 (2011).
Abdul, U. et al. GC–MS based metabolomic profiling of Aporosa cardiosperma (Gaertn.) Merr. Leaf extracts and evaluating its therapeutic potential. Sci. Rep. 14 (1), 16010 (2024).
Kumar, D. Nuclear magnetic resonance (NMR) spectroscopy for metabolic profiling of medicinal plants and their products. Crit. Rev. Anal. Chem. 46 (5), 400–412 (2016).
Beltran, A. et al. Assessment of compatibility between extraction methods for NMR-and LC/MS-based metabolomics. Anal. Chem. 84 (14), 5838–5844 (2012).
Wu, H. et al. High-throughput tissue extraction protocol for NMR-and MS-based metabolomics. Anal. Biochem. 372 (2), 204–212 (2008).
Alothman, A. et al. Metabolomics-based analysis of the diatom Cheatoceros tenuissimus combining NMR and GC–MS techniques. MethodsX 12, 102695 (2024).
Bennici, G. et al. Methods of extraction, detection, and identification of different metabolites—A metabolomics approach. In Metabolic Dynamics in Host-Microbe Interaction, 33–49 (Springer, 2025).
Gogna, N., Hamid, N. & Dorai, K. Metabolomic profiling of the phytomedicinal constituents of carica Papaya L. leaves and seeds by 1H NMR spectroscopy and multivariate statistical analysis. J. Pharm. Biomed. Anal. 115, 74–85 (2015).
Saeed, N., Khan, M. R. & Shabbir, M. Antioxidant activity, total phenolic and total flavonoid contents of whole plant extracts Torilis leptophylla L. BMC Complement. Altern. Med. 12, 1–12 (2012).
Selegato, D. M., Pilon, A. C., Carnevale, F. Plant metabolomics using NMR spectroscopy. In NMR-Based Metabolomics: Methods and Protocols, 345–362 (2019).
Emwas, A. H. et al. NMR as a gold standard method in drug design and discovery. Molecules 25 (20), 4597 (2020).
Emwas, A. H. et al. Recommendations for sample selection, collection and Preparation for NMR-based metabolomics studies of blood. Metabolomics 21 (3), 66 (2025).
Salem, M. A. et al. Metabolomics in the context of plant natural products research: from sample Preparation to metabolite analysis. Metabolites. 10(1). (2020).
Mahrous, E. A. & Farag, M. A. Two dimensional NMR spectroscopic approaches for exploring plant metabolome: A review. J. Adv. Res. 6 (1), 3–15 (2015).
Emwas, A. H. et al. Recommendations and standardization of biomarker quantification using NMR-based metabolomics with particular focus on urinary analysis. J. Proteome Res. 15 (2), 360–373 (2016).
Nagana Gowda, G. & Raftery, D. Quantitative NMR methods in metabolomics. In Metabolomics and its Impact on Health and Diseases, 143–164 (Springer, 2022).
Kim, H. K., Choi, Y. H. & Verpoorte, R. NMR-based metabolomic analysis of plants. Nat. Protoc. 5 (3), 536–549 (2010).
Abdul Jameel, A. G. et al. Calculation of average molecular parameters, functional groups, and a surrogate molecule for heavy fuel oils using 1H and 13 C NMR spectroscopy. (2016).
Abdul Jameel, A. G. et al. Predicting fuel ignition quality using 1H NMR spectroscopy and multiple linear regression. Energy Fuels. 30 (11), 9819–9835 (2016).
Al-Nemi, R. et al. Untargeted metabolomic profiling and antioxidant capacities of different solvent crude extracts of ephedra foeminea. Metabolites 12 (5), 451 (2022).
Rehman, Z. U. et al. Advanced characterization of dissolved organic matter released by bloom-forming marine algae. Desalination Water Treat. 69, 1–11 (2017).
Christaki, E. et al. Aromatic plants as a source of bioactive compounds. Agriculture 2 (3), 228–243 (2012).
Dhahri, M. et al. Extraction, characterization, and anticoagulant activity of a sulfated polysaccharide from bursatella Leachii viscera. ACS Omega. 5 (24), 14786–14795 (2020).
Evstigneyev, E. I. et al. Solid-State 13 C CP/MAS NMR for Alkyl-O-Aryl bond determination in lignin preparations. J. Wood Chem. Technol. 38 (2), 137–148 (2018).
Alvarez, S. & Naldrett, M. J. Mass spectrometry based untargeted metabolomics for plant systems biology. Emerg. Top. Life Sci. 5 (2), 189–201 (2021).
McCauley, J., Zivanovic, A. & Skropeta, D. Bioassays for anticancer activities. In Metabolomics Tools for Natural Product Discovery: Methods and Protocols, 191–205 (2013).
Hameed, E. S. S. et al. Phytochemical studies and evaluation of antioxidant, anticancer and antimicrobial properties of Conocarpus erectus L. growing in Taif, Saudi Arabia. Eur. J. Med. Plants. 2 (2), 93–112 (2012).
Khan, T. et al. Anticancer plants: A review of the active phytochemicals, applications in animal models, and regulatory aspects. Biomolecules 10 (1), 47 (2019).
Eweas, A. F., Alhossary, A. A. & Abdel-Moneim, A. S. Molecular docking reveals Ivermectin and Remdesivir as potential repurposed drugs against SARS-CoV-2. Front. Microbiol. 11, 592908 (2021).
Wang, M. et al. Remdesivir and chloroquine effectively inhibit the recently emerged novel coronavirus (2019-nCoV) in vitro. Cell Res. 30 (3), 269–271 (2020).
Handa, Y. et al. Prediction of binding pose and affinity of Nelfinavir, a SARS-CoV-2 main protease repositioned drug, by combining docking, molecular dynamics, and fragment molecular orbital calculations. J. Phys. Chem. B. 128 (10), 2249–2265 (2024).
Rosheen, S., Sharma & Utreja, D. Salicylic acid: synthetic strategies and their biological activities. ChemistrySelect 8 (13), e202204614 (2023).
Nweze, C., Ibrahim, H. & Ndukwe, G. Beta-sitosterol with antimicrobial property from the stem bark of pomegranate (Punica granatum Linn). J. Appl. Sci. Environ. Manage. 23 (6), 1045–1049 (2019).
Luhata, L. P. & Usuki, T. Antibacterial activity of β-sitosterol isolated from the leaves of Odontonema strictum (Acanthaceae). Bioorgan. Med. Chem. Lett. 48, 128248 (2021).
Rezaei-Seresht, H. et al. Cytotoxic activity of caffeic acid and Gallic acid against MCF-7 human breast cancer cells: an in silico and in vitro study. Avicenna J. Phytomed. 9 (6), 574 (2019).
Maslikah, S. I. et al. Anticancer activity of phenolic leaves of Bidara (Ziziphus mauritiana) against breast cancer by in silico. In AIP Conference Proceedings (AIP Publishing, 2021).
Cruz, J. N. et al. In Silico evaluation of the antimicrobial activity of Thymol—Major compounds in the essential oil of lippia thymoides Mart. & Schauer (Verbenaceae). Molecules 27 (15), 4768 (2022).
Akbar, S. et al. Evaluation of the antioxidant, antimicrobial, and anticancer activities of dicliptera bupleuroides isolated compounds using in vitro and in silico studies. Molecules 26 (23), 7196 (2021).
Ali, S. et al. Natural Products Can Be Used in Therapeutic Management of COVID-19: Probable Mechanistic Insights, vol. 147, 112658 (Biomedicine & Pharmacotherapy, 2022).
Majumder, D., Das, A. & Saha, C. Catalase Inhibition an anti cancer property of flavonoids: A kinetic and structural evaluation. Int. J. Biol. Macromol. 104, 929–935 (2017).
Hussien, M. A., Sharfalddin, A. A. & Jaremko, M. In Silico Study Of Natural Compound Candidates As Promising Drugs For SARS-Cov-2. (2021).
Hussain, M. et al. Structural variations in human ACE2 May influence its binding with SARS-CoV‐2 Spike protein. J. Med. Virol. 92 (9), 1580–1586 (2020).
Bakrim, S. et al. Dietary phenolic compounds as anticancer natural drugs: recent update on molecular mechanisms and clinical trials. Foods 11 (21), 3323 (2022).
Alam, M. et al. Therapeutic implications of caffeic acid in cancer and neurological diseases. Front. Oncol. 12, 860508 (2022).
Maheshwari, N. & Sharma, M. Anticancer properties of some selected plant phenolic compounds: future leads for therapeutic development. J. Herb. Med. 42, 100801 (2023).
Chisca, S. et al. Crosslinked copolyazoles with a zwitterionic structure for organic solvent resistant membranes. Polym. Chem. 6 (4), 543–554 (2015).
Zhang, H. et al. Solid-state NMR spectroscopic analysis of sweet Cherry leaves under different cultivation patterns. HortScience 56 (2), 270–276 (2021).
Salem, M. A. et al. Protocol: a fast, comprehensive and reproducible one-step extraction method for the rapid Preparation of Polar and semi-polar metabolites, lipids, proteins, starch and cell wall polymers from a single sample. Plant. Methods. 12, 1–15 (2016).
Molole, G. J., Gure, A. & Abdissa, N. Determination of total phenolic content and antioxidant activity of commiphora mollis (Oliv.) Engl. Resin. BMC Chem. 16 (1), 48 (2022).
Alnoman, M. M. et al. New Co (II) schiff base complexes of 3-ethoxy-4-hydroxybenzaldehyde and Chlorophenyl ethylamine derivatives as potent antimicrobial agents: Design, synthesis, molecular docking, DFT calculations, and in Silico ADME profiles. J. Mol. Struct. 1307, 138021 (2024).
Sharfalddin, A. A. et al. Investigating the biological potency of Nitazoxanide-Based Cu (II), Ni (II) and Zn (II) complexes Synthesis, characterization and Anti-COVID-19, Antioxidant, antibacterial and anticancer activities. Molecules 28 (16), 6126 (2023).
Moosa, B. A. et al. Synthesis and anticancer evaluation of Spermatinamine analogues. Bioorg. Med. Chem. Lett. 26 (6), 1629–1632 (2016).
Sharfalddin, A. A. et al. Biological efficacy of novel metal complexes of nitazoxanide: Synthesis, characterization, anti-COVID-19, antioxidant, antibacterial and anticancer activity studies. J. Mol. Liq. 368, 120808 (2022).
Mioc, M. et al. Targeting anti-apoptotic bcl-2 proteins with triterpene-heterocyclic derivatives: a combined dual docking and molecular dynamics study. Molecules 30 (19), 3919 (2025).
GÖKALP, F., ERENLER, R. & ALMA, M. H. The investigation of the interaction of gastric cancer receptors and natural drug ligands in Origanum Bilgeri. Sigma 43 (3), 981–986 (2025).
Rochín-Medina, J. J. et al. Activity of plant essential oils against clinically and environmentally isolated Salmonella enterica serotypes: in vitro assays and molecular Docking. Lett. Appl. Microbiol. 76 (4), ovad045 (2023).
Balahbib, A. et al. Unlocking the Potential of Origanum Grosii Essential Oils: A Deep Dive into Volatile Compounds, Antioxidant, Antibacterial, and Anti-Enzymatic Properties Within Silico Insights, vol. 22 (2), e202401426 (Chemistry & Biodiversity, 2025).
Huang, Y. et al. Structural and functional properties of SARS-CoV-2 Spike protein: potential antivirus drug development for COVID-19. Acta Pharmacol. Sin. 41 (9), 1141–1149 (2020).
Acknowledgements
The authors would like to thank King Abdullah University of Science and Technology (KAUST) for providing access to GC-MS, and NMR Spectroscopy facilities to acquire and analyze data, and for assistance in operating the instruments and use of related software. The authors gratefully acknowledge the KAUST Analytical Chemistry Core Lab staff for their support and assistance. External editing by Dr. Kristin Strandenes, EddaTxT, Norway (eddatxt@outlook.com).
Funding
This research was funded by Mariusz Jaremko from grants (Baseline (BAS/1/1085-01-01)) received from KAUST and SHI.
Author information
Authors and Affiliations
Contributions
Conceptualization, A.D. and A.H.E.; methodology, A.D. and A.H.E.; validation, A.H.E., M.J. and S.S.; formal analysis, A.D., I.A.Y. and A.A.S.; investigation, A.D. and I.A.Y.; resources, K.S.; data curation, A.D. and A.H.E.; writing—original draft preparation, A.D., R.M., S.A.M., I.A.Y., A.A.S., M.A. and F.A.R.; review and editing, A.D. and A.H.E., M.J., S.S.; visualization, A.D. and F.A.R.; supervision, A.H.E. and M.J.; funding acquisition, M.J. All authors have read and agreed to the published version of the manuscript.
Corresponding authors
Ethics declarations
Competing interests
The authors declare no competing interests.
Ethics Statement
The article does not contain any human or animal studies.
Additional information
Publisher’s note
Springer Nature remains neutral with regard to jurisdictional claims in published maps and institutional affiliations.
Supplementary Information
Below is the link to the electronic supplementary material.
Rights and permissions
Open Access This article is licensed under a Creative Commons Attribution-NonCommercial-NoDerivatives 4.0 International License, which permits any non-commercial use, sharing, distribution and reproduction in any medium or format, as long as you give appropriate credit to the original author(s) and the source, provide a link to the Creative Commons licence, and indicate if you modified the licensed material. You do not have permission under this licence to share adapted material derived from this article or parts of it. The images or other third party material in this article are included in the article’s Creative Commons licence, unless indicated otherwise in a credit line to the material. If material is not included in the article’s Creative Commons licence and your intended use is not permitted by statutory regulation or exceeds the permitted use, you will need to obtain permission directly from the copyright holder. To view a copy of this licence, visit http://creativecommons.org/licenses/by-nc-nd/4.0/.
About this article
Cite this article
Dutta, A., Al-Younis, I., Manassra, R.I. et al. NMR and GC-MS based metabolic profiling, total phenolic content, antibacterial, antioxidant, anticancer and In-silico antiviral activity of Origanum ramonense plant. Sci Rep 15, 42451 (2025). https://doi.org/10.1038/s41598-025-26621-w
Received:
Accepted:
Published:
Version of record:
DOI: https://doi.org/10.1038/s41598-025-26621-w